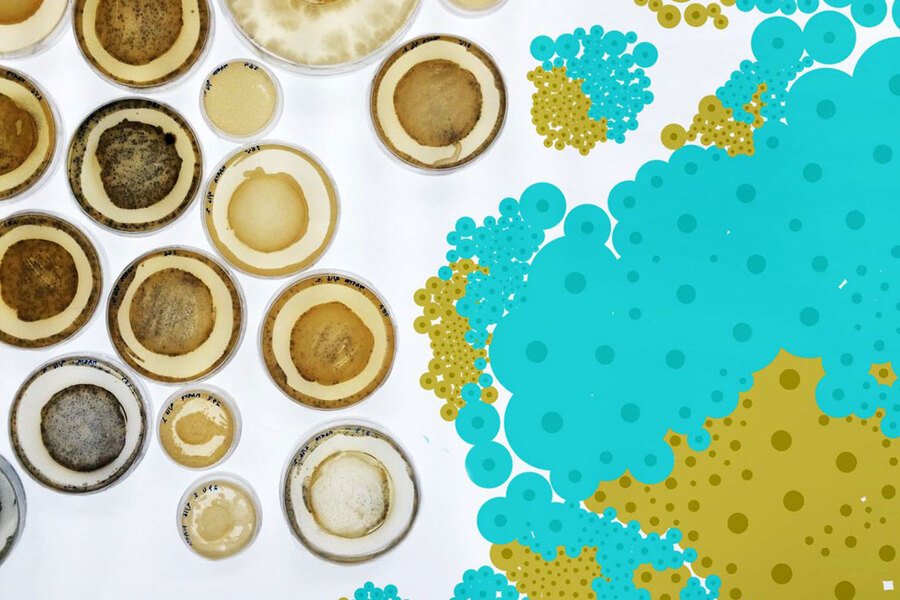
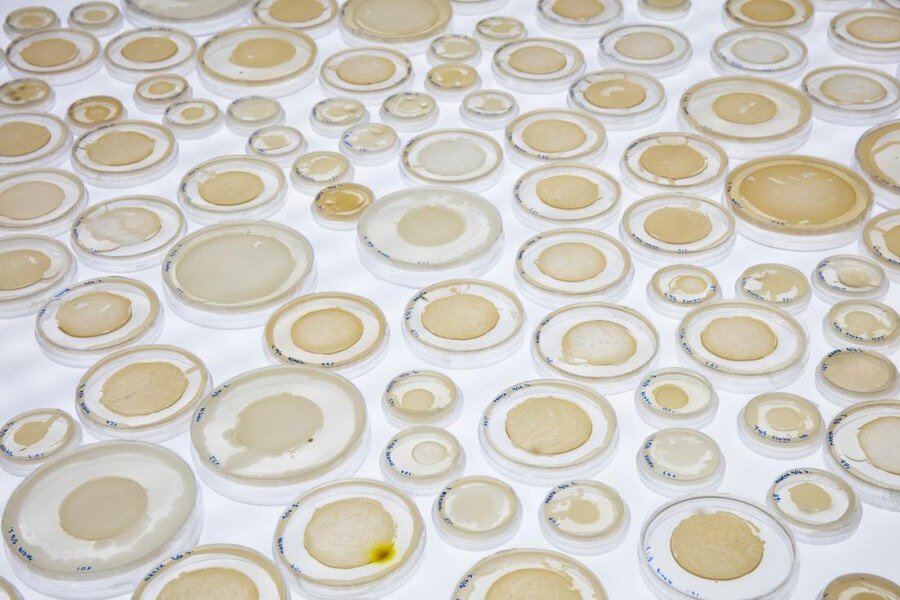
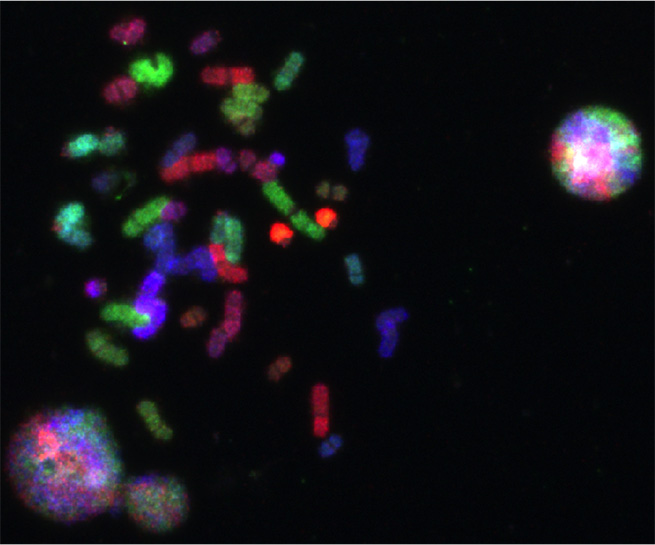

Исполнять науку: о лабораторно-технической эстетике Art&Science
Публикуемый ниже текст — фрагмент статьи «Art& Science и постгуманизм: технонаука, эстетика и телесность», ставшей итогом совместного междисциплинарного исследования. Полный текст см. здесь. Другой результат того же исследования, сосредоточенный на метафизическом анализе Art& Science см. в первом номере «Логоса» за 2024 год, посвященном художественным исследованиям.
Знак «&» из Art& Science — краеугольный камень этого художественного направления. Обычно его интерпретируют как «встречу», «союз», «синтез», «коллаборацию» или «переплетение». Это в лучшем случае говорит нам о том, что такое искусство создается художником и ученым или инженером, будь то разные люди или ипостаси одного и того же человека. Но что, собственно, они делают, создавая свои работы? Как эта конъюнкция работает? Речь ведь, очевидно, не о механическом соединении двух компонентов.
Характер связи между A& S и технонаукой варьируется от проекта к проекту. Научные знания, онтологии и техники могут быть средством или темой для этого искусства, могут приниматься некритически или подвергаться изучению и критике с точки зрения своих социально-политических последствий. Одни проекты A& S делают темой вмешательство технонауки в жизнь обществ, другие предпочитают замыкаться в границах природных процессов и игнорировать социальные контексты. Никакой из этих аспектов, с нашей точки зрения, не является определяющим для данного художественного поля.

Marta DeMenezes. Tree of Knowledge. 2011
Многообразие A& S усложняется тем, что нет единой концептуальной и художественной программы вроде программ модернистского искусства, которая бы устанавливала цели и средства, позиционировала A& S относительно современного искусства и принималась большинством представителей этого искусства. Есть сложившиеся практики, эстетические решения, проблематики и темы.
Отчасти поэтому A& S гибко и может одинаково хорошо чувствовать себя и как высоколобое искусство в белых кубах галерей, и как технологический аттракцион на площадках популяризации науки, и как остросоциальный активистский перформанс, и как инструмент маркетинга для научных лабораторий и технологических корпораций, и как способ развития креативности сотрудников компаний.
Мы сформулируем рабочее определение A& S, сосредоточившись на связи между искусством и технонаукой в контексте постгуманистической проблематики, в частности критики знания. Дело в том, что в постчеловеческом настоящем «власть репрезентации в производстве знания становится все менее невинной, если она вообще когда-либо такой была» (Феррандо, 2022a, с. 127). Поэтому мы обратимся к критическому анализу производства знания, а именно к тем подходам исследований науки и техники (STS), которые обычно маркируются как онтологический конструктивизм и связаны с акторно-сетевой теорией (эти подходы — часть генеалогии постгуманизма, но также и предмет критики с его стороны). Здесь мы воспользуемся подходом Джона Ло, который суммирует идеи и исследования своих коллег в книге «После метода» (Ло, 2015, с. 44-98).
Marta DeMenezes. (UN)BIASED. 2017
Анализируя исследования лаборатории, проведенные Бруно Латуром и Стивеном Вулгаром, Ло показывает, что реалии природы — нечто, считающееся существующим самостоятельно (causa sui), независимо от человека и обладающим собственным устройством, определенностью и предшествующее познанию, — на деле возникают как результат научного исследования, проводимого в лаборатории.
То есть, природные реалии осуществляются (being enacted) технонаукой, а не предшествуют ей, ожидая, когда она их откроет.
Реалии природы (на самом деле и общества) существуют, пока на их существование работает соответствующая материально-когнитивная инфраструктура, включающая теории, технику и лаборатории, материалы, ученых и их компетенции, научные, метрологические и образовательные институты и т. д. Эта разнородная сеть обеспечивает возможность познания и манипуляций тем, что объявляется природой.
Например, нечто, существующее для нас как электрон — это складка научного понятия, техники и сопротивления вещей, осуществляемая в лабораториях как природная реалия. Конструируемая, но реальная. Как только сеть, осуществляющая электрон, по какой-то причине распадется (скажем, в результате появления более эффективной физической теории с другой онтологией или вследствие катастрофических событий и стремительной постапокалиптической архаизации, как в фантастике), его существование окажется под вопросом, а скорее всего постепенно прекратится.
[…]
Paul Vanouse. The America Project. 2017
«Невозможно изолировать друг от друга: а) производство отдельных реалий; б) производство утверждений об этих реалиях; в) создание технических, инструментальных, человеческих конфигураций и практик, устройств записи, производящих эти реалии и утверждения. Все это производится вместе» (Ло, 2015, с. 69).
Скажем, электрон осуществляется технонаукой в качестве природной, независимой вещи: различия природы и культуры, внутреннего и внешнего — эффекты работы разнородной сети (Ло, 2015, с. 66), а не координатная сетка, в которой эта работа разворачивается.
Однако эта сконструированность природных реалий остается для нас невидимой, так как по окончании успешного исследования, показывает Ло, вся цепочка действий ученых и техническая инфраструктура стираются из репрезентации результата, чтобы сделать его безусловным и самодостаточным. Мы остаемся один на один с объектом, который теперь предъявляется как природный, предшествовавший исследованию и, наконец, в результате исследования корректно выделенный и описанный. Объект натурализируется: отвязывается от технонаучной сети как условия своего осуществления и объявляется всегда уже существовавшим, с необходимостью именно таким, а не иным.
Отношения переворачиваются: то, что появилось как результат исследования, становится его причиной, а наука из конструирования и осуществления превращается в процесс открытия, в «зеркало природы» (Ло, 2015, с. 79-83).
Одна из задач STS, изучающих практики ученых и материальность науки, — проследить технонаучные процессы, выявить описанное переворачивание и тем самым денатурализировать технонаучно осуществляемую природу, показав, что эта природа — не судьба, могла быть осуществлена другая. Этот ход имеет значение в широком контексте.
Во-первых, он позволяет проблематизировать эссенциализмы, укореняющие социальные или этические отношения в природе как универсальном и незыблемом основании, а также подвесить попытки вывести этическую или социальную нормативность из природных реалий (Daston, 2019).
Во-вторых, это значит, что осуществление реалий не определяется только сопротивлением самих вещей и могут быть иные факторы — социальные, политические, культурные и т. д. Оно неразрывно связано с онтологической политикой и вопросом о благе (Ло, 2015, с. 293-311; Mol, 1999).
Осуществление природных реалий (и человеческого тела в том числе) — социальный и политический акт, опосредованно перераспределяющий блага, возможности и ограничения по-разному для разных социальных групп и обществ.
Но если познание перформативно, если возможен иной исход, то осмысленно спрашивать, в силу каких выборов и предпочтений реалии осуществляются именно так, а не иначе, именно такими, а не иными?
Как сделать так, чтобы их осуществление вело к лучшему положению дел для всех — лучшему обществу, лучшему распределению благ и т. д.?
Marta DeMenesez. The Origin of Species — Post Evolution — Drosophila / Wolbachia. 2018
Лабораторно-техническая эстетика Art& Science
Мы сосредоточимся на специфической материальности работ Art& Science. Какое бы отношение к технонауке ни выстраивал художник, какие бы цели ни преследовал, он обычно следует своеобразной лабораторно-технической эстетике.
Выставка «Да живет иное во мне». Третьяковская галерея. 2021
В проектах A& S мы видим рабочие объекты научных теорий (химические соединения, клетки, тела, водоросли и растения, лабораторные организмы, минералы, электромагнитные волны, частицы), но прежде всего научные приборы и технические устройства, причем как правило их внутреннее устройство нарочито раскрыто, даже обнажено. Здесь булькающие сосуды, инкубаторы, пробирки, стекла, провода, шланги, соединения, сервоприводы, насосы, батареи, микросхемы, мониторы с типичными научными образами и прочие элементы лабораторно-технической обстановки.
Лабораторно-техническая эстетика чаще обоснована, поскольку экспонируемые технические устройства необходимы для осуществления (или воспроизводства) проектов. Вот несколько примеров.
В 2000 году на фестивале Ars Electronica австралийская научно-художественная лаборатория SymbioticA (Орон Каттс, Ионат Цурр, Гай Бен-Ари) показал проект The Semi-living Worry Dolls, в котором впервые экспонировались «полуживые» скульптуры. Это куклы, выращенные из клеток кожи, мышц и костей в биореакторе на разлагаемой полимерной матрице и затем сшитые хирургическими нитками. Для поддержания их состояния требовалась лабораторная оснастка. Скульптуры отсылали к гватемальским «куклам беспокойства», которым дети по вечерам могли нашептывать свои тревоги. То же самое предлагалось сделать и посетителям: каждая кукла специализировалась на конкретной тревоге — о людях, верящих в абсолютную истину, злоупотреблениях биотехнологиями, капитализме, евгенике, редактировании ДНК и т. д.
1,2,3 — Oron Catts, Ionat Zurr & Guy Ben-Ary. Semi-living Worry Dolls, 2000. 4 Worry Dolls, etsy.com
В проекте In Posse (2020) художница Шарлотта Джарвис и биолог Сюзанна де Соуза Лопес из Медицинского центра Лейденского университета создавали сперматозоиды и спермоплазму из клеток женского тела. Это требовало высокотехнологичной лаборатории и стало возможно благодаря изобретению инструмента редактирования ДНК CRISPR/Cas9 и открытию перепрограммирования зрелых клеток в плюрипотентные.
Charlotta Jarvis. In Posse. 2020. Female semen and different installations
В свою очередь, словенская художница Саша Спачаль в сотрудничестве с биологами и инженерами создает в галереях сложные инсталляции на основе лабораторного и медицинского оборудования. Она моделирует или воспроизводит планетарные метаболические процессы между человеком, другими организмами и минеральными агентами, чтобы тематизировать постчеловеческое в биополитике и некрополитике настоящего времени.
Например, Inspiration (2018) — это дыхательная станция, которая подает через респираторные маски воздух, обогащенный почвенными бактериями Mycobacterium vaccae. Эти бактерии работают как антидепрессанты, повышающие уровень серотонина. (Спачаль отмечает, что они притупляют эмоции, в том числе романтическую влюбленность в другого человека, открывая путь для иных видов любви, в том числе к нечеловекам.) При этом воздух распределяется между посетителями неравномерно. Когда дыхание становится технически опосредованным, встает вопрос о том, кто контролирует технику, насыщение и распределение воздуха — кто задает ритм и качество дыхания?
Saša Spačal. Inspiration. 2018
Проект Guest (2019), часть «Геологической трилогии» российского художника Дмитрия Морозова (: vtol:), — это технологичная инсталляция из трех роботизированных механизмов, посвященная падению Сихотэ-Алинского метеорита в Приморском крае в 1947 году. Она циклически воспроизводит это событие: нагревание осколка металлического метеорита до температуры падающего метеорита в верхних слоях атмосферы — потеря им магнитных свойств — отмагничивание от манипулятора и падение — остывание — возвращение магнитных свойств — примагничивание к манипулятору и нагревание. Этапы этого цикла преобразуются в изображение и звук. Инсталляция сооружалась Морозовым и в экспозиционных пространствах, и в кратере Сихотэ-Алинского метеорита.
Для искусства перечисленных художников и художниц лабораторно-техническое оборудование необходимо так же, как, скажем, видеокамера и экран нужны в видео-арте. Иногда удается устроить функционирующую лабораторную установку в стенах галереи. Иногда это невозможно, и результат (и/или его документация), необходимый для проекта, получается в лаборатории, а затем переносится в галерею вместе с лабораторным оборудованием, теперь уже играющим роль декорации.
В других случаях лабораторно-техническая эстетика не обусловлена лабораторным происхождением проекта. Так, тайваньский художник Куанг-И Ку использовал лабораторную эстетику при экспонировании иронического проекта Tiger Penis Project (2019). В этом проекте он создавал из ортодонтической смолы реалистичные скульптурные объекты, напоминающие органы животных, и предлагал готовить из них и из трав препарат, улучшающий потенцию. Этот воображаемый препарат был призван заменить лекарства китайской народной медицины, для приготовления которых истребляются редкие виды животных, ассоциирующиеся в китайской культуре с мужской силой. Придуманная им инсталляция в лабораторном стиле — гипотеза, как могла бы выглядеть лаборатория биопечати таких органов, если бы воплотилась в жизнь.
Kuang-Yi Ku. Tiger Penis Project. 2019
Kuang-Yi Ku. Tiger Penis Project. 2019
Kuang-Yi Ku. Tiger Penis Project. 2019
Перформанс технонауки
Проекты A& S, использующие лабораторно-техническую эстетику, по сути, предъявляют зрителю прежде всего саму технонаучную инфраструктуру, которая, с точки зрения STS, осуществляет природу, а затем уже и природу в виде клеток, молекул, химических соединений, явлений магнетизма и т. д. На уровне технонаучного медиума — если не проваливаться сквозь его «поверхность» в ожидаемое пространство автономной природы — здесь происходит не чистый акт представления природных вещей, а представление представления: раскрытие материально-дискурсивного условия возможности природы.
Если технонаука — это осуществление природных реалий, то Art& Science — это осуществление самой технонауки как осуществляющей природные реалии сети, ее исполнение, перформанс.
Такое осуществление может принимать разную форму — от буквального воспроизводства до иронического разыгрывания и пародирования. A& S — это упражнение в современной эмпирической метафизике, которая учитывает уроки STS и постструктурализма: преимущественный способ быть в мире антропоцена — быть осуществляемым сетями технонаучных практик. В этом смысле A& S — реэнактмент технонаучного конструирования современного мира.
Перформанс или разыгрывание технонауки в A& S — на поверхности, это буквально первое, что видит зритель.
Однако оно чаще остается для него невидимым подобно стеклу в окне, в котором уже виднеется природа. Срабатывают узнаваемые образы и нарративы лабораторности и научности, которые ассоциируются с прорывом науки к самой природе и производят эффект реалистичности и достоверности. По сути же в проектах A& S природные реалии возвращаются в сценографию условий их осуществления, производства технонаукой. Пока мы удерживаем во внимание технонауку как осуществляющий природу медиум, не позволяя стереть ее продуктивность, не совершается и тот натурализирующий поворот, который предает ее забвению и превращает результат исследования в причину.
Независимо от намерений художников в конкретных проектах это искусство может возвращать природе (и иногда технике) условия ее рождения и существования, то есть всю ту разнородную технонаучную сеть, которая нужна для ее осуществления. Таким образом может происходить денатурализизация природы. Так понятая лабораторно-техническая эстетика A& S является постгуманистической.
Библиография
Кант И. (1994) Критика чистого разума // Кант И. Собрание сочинений в восьми томах. М.: Издательство «Чоро». Т. 3. Кралечкин Д. (2002) Фундаментальное различие бытия и сущего как способ обоснования онтологии. Дисс. на соискание ученой степени канд. филос. наук. Москва: МГУ. Ло Д. (2015) После метода: беспорядок и социальная наука. М.: Издательство Института Гайдара, 2015. Феррандо Ф. (2022a) Феминистская генеалогия эстетики постчеловеческого в визуальных искусствах // Логос. № 1. С. 123-166. Mol A. (1999) Ontological Politics. A Word and Some Questions // The Sociological Review. No 1. P. 74-89.
В оформлении обложки использована работа Alicia King. The Vision Splendid, 2011